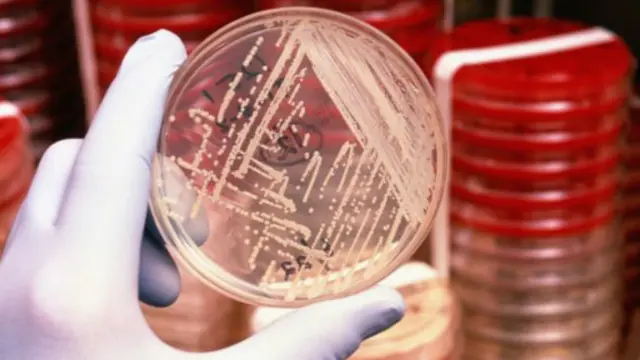

美国发现对抗生素最后防线有耐药性细菌
图像来源,SPL
美国发现首例对抗生素最后一道防线 --粘杆菌素 -- 有抗药性的感染病例。
宾夕法尼亚州一名48岁女士已经康复,而其感染对其他抗生素有反应。
但是由于其他药物失效,因此粘杆菌素非常有象征意义。官员们警告说,全世界接近走到抗生素“这条路的尽头”。
粘杆菌素耐药性首先是2015年在中国发现的。
这项研究在全球引起关注,深度检测在欧洲和亚洲迅速发现了抗粘杆菌素的细菌。
美国的新数据在一名尿道感染病人身上以及农庄牲畜和超市的肉类产品上鉴别了首个案例。
不清楚感染是如何发生的,因为这名病人最近没有旅行记录,而粘杆菌素在美国也没有广泛使用。
前景暗淡
使细菌能抵抗粘杆菌素的DNA -- mcr-1gene -- 能在不同种群中迅速扩散。
人们担心的是粘杆菌素耐药细菌将同能抵抗其他抗生素的细菌结合起来,导致无药可治的感染。
疾病控制和预防中心主任托马斯·弗莱登(Thomas Frieden)说,“我们越研究耐药性,我们就越感到担忧。”
“对一些病人来说,已经没有可以医治他们病的药物了,如果我们不采取紧急行动,抗生素这条路已经到了尽头。”
但是疾病控制和预防中心的贝斯·贝尔博士(Beth Bell)说,“幸运的是,我们还没有看到对所有抗生素都有耐药性的细菌。”








